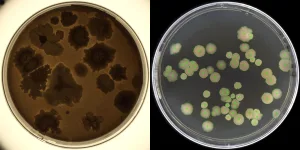

Traditional manual colony counting relies entirely on the visual judgment and manual tallying of laboratory personnel, leading to significant issues of subjective bias. Different operators often produce substantial discrepancies due to inconsistent judgment criteria in areas such as colony morphology identification, splitting overlapping colonies, and recognizing micro-colonies. More critically, the manual recording mode presents challenges with data traceability and lack of oversight. Due to the absence of convenient and reliable verification methods, some laboratories are compelled to implement a “second person verification” mechanism, where another technician performs a secondary count of colonies on the same sample Petri dish, serving as supplementary assurance for data accuracy.

It is evident from the above regulations and guidelines that when traditional manual counting and paper records are employed, a second person verification is generally required. However, when electronic information technologies like automated colony counters are used, which significantly reduce data integrity risks, second person review of the results is not necessarily mandatory.
In USP <1117> Microbiological Best Laboratory Practices, based on the limitations of traditional colony counting, it is not recommended to mechanistically apply simultaneous reading by a second analyst to all samples and microbiological tests.Instead, simultaneous verification by a second analyst may be implemented for high-risk testing. The compendium describes it as follows:

USP<1117> also mentions that most colony counters currently available on the market still face challenges, such as difficulties in distinguishing overlapping colonies and differentiating particles from colonies. Automated counting methods utilizing image stacking technology to capture the dynamic growth of colonies over time may overcome some of these technical difficulties.

Tailin Automatic Colony Counter Workstation (SCW Series) employs multiple innovative technologies. Utilizing image tracking and neural network algorithms, combined with multi-temporal configuration technology, dynamic real-time detection technology, and local region analysis, it captures the dynamic growth process of colonies over time, enabling precise counting of colonies growing on plates.

Particularly, its time-lapse image AI analysis technology achieves automatic segmentation of agglomerated or confluent colonies by analyzing morphological changes during dynamic colony growth, annotates colony contours, automatically eliminates particles and impurities, and accurately identifies edge colonies. Colonies are identified and counted as soon as they appear, significantly overcoming the current technical shortcomings of automated colony counters.

Furthermore, Tailin Automatic Colony Counter Workstation SCW Serie simplements an automated system that performs continuous counting during the incubation process. It can store original images, save videos of the colony growth process, and output colony growth curves and reports; equipped with audit trail functionality to ensure data integrity and reliability.
Current regulatory requirements and operational practices regarding the necessity of a second person independent verification for Petri dish colony counting require comprehensive consideration based on rigorous risk assessment and technological advancement. With the significant improvements in accuracy, traceability, and compliance offered by automated colony counting systems, the verification model for microbiological enumeration is gradually evolving. Validated fully automated platforms can effectively reduce reliance on traditional manual dual verification while ensuring data integrity, thereby optimizing testing workflows and enhancing overall efficiency and reliability.
Technical & inquiry : marketing@tailingood.com
Reference Regulations & Guidelines:
[1] PIC/S GUIDANCE PI 041-1: Good Practices For Data Management And Integrity In Regulated GMP/GDP Environments
[2] PDA Technical Report No. 80 (TR 80): Data Integrity Management System for Pharmaceutical Laboratories (single user digital version)
[3] WHO ECSPP TRS 1033 Annex 4 Guideline on data integrity
[4] FDA Data Integrity and Compliance With Drug CGMP: Questions and Answers; Guidance for Industry
[5] USP <1117> Microbiological Best Laboratory Practices